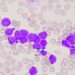

Lung cancer happens when cells in your lungs get changes (mutations) that cause them to grow and divide uncontrollably. These cells form masses, or tumors, that keep your lungs from working properly.
The type of lung cancer you have tells you what kind of cell it started in. Knowing this helps your doctor decide which treatment you need.
Small Cell Lung Cancer
Small cell lung cancer forms in the tissues of the lungs. The lungs are a pair of cone-shaped breathing organs in the chest that bring oxygen into the body and remove carbon dioxide when you breathe. They have sections called lobes, and small tubes called bronchioles lead from the trachea (windpipe) to the lungs. The lungs also have tiny air sacs called alveoli where oxygen is absorbed. The lungs are wrapped in a thin membrane called the pleura. Small cell lung cancer grows more quickly than non-small cell lung cancer and spreads more easily to other parts of the body.
Smoking or having a history of smoking is the main risk factor for this type of lung cancer. But the disease can also be caused by exposure to certain chemicals or other factors. For example, the lining of the lungs can be damaged by asbestos and other toxic fumes. Other causes of the disease include exposure to radiation from medical tests or treatments, and the natural radioactive gas radon.
Healthcare providers diagnose this disease by doing a physical exam and taking your medical history. They may use imaging scans such as computed tomography (CT) or positron emission tomography/CT to find the tumor and see how far it has grown. A needle biopsy can also show whether the cells are cancerous.
Treatment options for small cell lung cancer depend on the stage of the disease and how it has spread to other parts of the body. For the most common types of SCLC, doctors can surgically remove the tumor. They may also use chemotherapy drugs to shrink the tumor and keep it from coming back after surgery or spreading further.
For advanced-stage SCLC, surgery cannot cure the disease. But it can help ease symptoms and improve quality of life. Doctors treat this disease with combinations of medications that include the drugs carboplatin (Paraplatin), cisplatin (Platinol AQ), docetaxel (Taxotere), etoposide (Vepesid), doxorubicin (Adriamycin, Rubex), and irinotecan (Camptosar).
Other treatments may include targeted therapy or radiation to the brain. These treatments can be given in combination or alone. They can also be given to people who have other health problems, such as bone metastases or liver disease.
The information in this summary is based on a review of published research. It is provided for educational purposes only and is not intended to replace the advice of your doctor or other health care provider. We encourage you to discuss any questions or concerns you may have with your provider. This PDQ cancer information summary has been reviewed and approved by the National Cancer Institute (NCI). It is updated regularly, as new information becomes available. The NCI PDQ cancer information summaries are written by NCI staff members in collaboration with experts from other federal agencies and private organizations. They are peer-reviewed, evidence-based, and include information about the effectiveness of a particular treatment. The PDQ cancer information summaries are produced by the NCI’s Division of Cancer Prevention and Control and are part of the National Cancer Institute’s (NIH) comprehensive cancer database.
Treatment
Cancer cells grow in your lungs, which are a pair of cone-shaped organs in your chest. The lungs bring oxygen into the body and release carbon dioxide, a waste product of cell metabolism. The lungs have sections called lobes, and two tubes (bronchi) lead from the windpipe to the right and left lungs. If lung cancer develops, it may grow into the lungs and spread to other parts of the body.
You can’t prevent lung cancer, but you can take steps to lower your risk by not smoking or stopping if you do. Getting regular screening tests can also help detect the disease in its early stages.
To diagnose lung cancer, your doctor will order X-rays and other imaging tests, such as CT, PET or MRI scans. If the results suggest lung cancer, a biopsy can be performed to remove a sample of the tumor for further testing. To perform a lung biopsy, your doctor will insert a tube through the mouth or nose (bronchoscopy). This tube allows him or her to view and sample tissue inside the lungs. Genetic testing can also be done on the tissue to identify specific details about your cancer that can guide treatment.
Your treatment will depend on the type of lung cancer you have and whether it has spread. Yale Medicine offers surgery, chemotherapy, radiation therapy and targeted therapy for NSCLC.
Chemotherapy uses anti-cancer drugs that kill cancer cells or stop them from growing by binding to them. The drug can be given by injection into a vein (intravenous or IV) or by taking a pill (oral). When used in combination with surgery and/or radiation therapy, it can improve survival and control symptoms.
Targeted therapy uses anti-cancer drugs that are designed to attack specific details of your cancer, such as the genes or proteins that drive its growth. These therapies include monoclonal antibodies, tyrosine kinase inhibitors, mammalian target of rapamycin inhibitors and KRAS G12C inhibitors.
NSCLC can spread to other parts of the body, including your bones, liver, brain and lymph nodes. When this happens, it’s called metastatic non small cell carcinoma. Yale Medicine doctors are leaders in the field of immunotherapy, a type of treatment that works with your immune system to fight cancer.